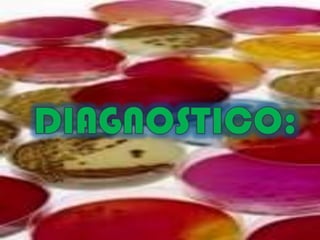

Incrustar presentación
Descargado 123 veces


















Este documento lista diferentes tipos de medios de cultivo para realizar pruebas microbiológicas, incluyendo agar EMB, agar MacConkey, agar de sangre, agar urea, agar manitol y agar Simmons con sacarosa y citrato.